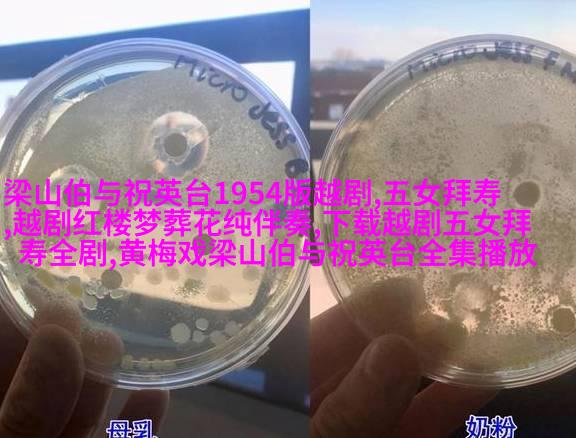

江南水乡的歌:越剧之美与我

一、越剧的传统魅力
在浙江绍兴的一片繁华中,越剧如同一道悠扬的旋律,穿透了时间的长河,保留着古老文化的精髓。它不仅是一种表演艺术,更是对历史和地域文化的一次深刻回忆。

二、舞台上的诗意画卷
每一次观看越剧表演,都仿佛置身于千年前的江南水乡。那些优雅婉约的女伶们,用她们那细腻的情感和精湛的手法,将戏曲中的情感深入人心。他们通过轻盈而优雅的手势,以及清脆悦耳的声音,让观众仿佛能看到那被沧桑时光洗礼过的小桥流水。
三、音乐与舞蹈交融
越剧之所以能够如此深受人们喜爱,其实质在于它独特的地理环境所塑造出的音乐风格与舞蹈技巧。在这个过程中,每一个动作都蕴含着丰富的情感,对观众来说,它既是一种视觉享受,也是精神上的愉悦。

四、讲述故事的心灵手足
从《琵琶记》到《牡丹亭》,从《白蛇传》到《西厢记》,这些经典作品不仅展现了作者对生活细节的精准描绘,还反映出了那个时代的人文关怀。在这样的背景下,我们可以更好地理解那些往昔英雄豪杰背后的故事,他们用自己的智慧和勇气,为我们今天留下了一份宝贵的心血。

五、现代化发展下的挑战与机遇
随着社会进步和科技发展,越剧也面临着新的挑战。如何将这门古老艺术形式结合现代元素,以吸引更多年轻人的注意?这是每一位参与者必须面对的问题。这也是一个机遇,因为只有不断创新,不断适应,可以使越剧更加广泛地传播开来,让更多人了解并欣赏这门艺术。
六、心得体会:爱与共鸣
每当我沉浸在一场精彩绝伦的越剧表演中,我都会感到一种难以言喻的情感,那是对于这门艺术形式最真挚的情感。我明白,这不仅仅是一种审美体验,更是一种文化认同,是一种跨时空交流的情感共鸣。我相信,只要有这样的心态去拥抱,这世间万象,就能让我们的灵魂得以飞翔。


